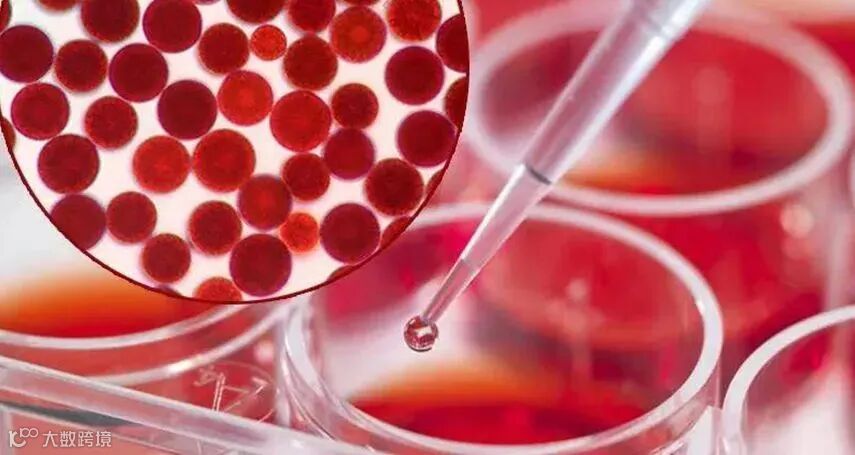

最近,虾青素很是火爆。保健食品、功能食品、化妆品都在用,抗衰老,美白肌肤,男人女人都喜欢,网上平台关键词一搜,成千上万的结果跃入眼帘。虾青素到底有没有那么神?带着这个疑问,我们去了解下这个东西,看看到底有没有这么回事。
虾青素,为雨生红球藻提取物,天然类胡萝卜素抗氧化营养素,抗氧化能力是维生素E的550倍,虾青素分子结构中富含大量不饱和键,可以淬灭人体中氧自由基,减少氧自由基对人体组织细胞的攻击,减少人体疾病的发生,对眼和中枢神经系统具有一定的保护作用,同时还具有预防心血管疾病,改善人体认知能力、增强免疫力、抗炎抗感染、缓解运动疲劳、增强机体能量代谢、抑制糖尿病肾病及抑制肿瘤等抗衰老的功能。

以上都为文献报道的内容,已有试验数据支撑,我们就不去质疑了。但是这种描述简直是“包治百病”或者说可“预防百病”的说法是否科学呢?让我们深入了解下。

首先大家可以思考下,我们生活在这个社会中,平日里身体会受到哪些侵害或伤害呢? 整体来说分外源性伤害和内源性侵害,外源性伤害包括机械伤害和非机械伤害两种,其中机械伤害如被打击,被割伤,被摔骨折等等,而非机械伤害有空气污染毒害,毒素毒害等等。
内源性侵害包括有害微生物侵害和自由基侵害两种,其中有害微生物的侵害是我们经常接触到和了解比较多的一种侵害,包括有害细菌和病毒对人体的侵害,这个侵害是存在于人体整个生命过程,人体通过自身免疫系统来对抗这种侵害,使得我们身体保持正常的生存状态。当这种对抗状态出现问题时,我们就会出现病症,如炎症,咳嗽,腹泻等等症状,这个时候就需要使用抗生素等药物来加强对抗这种有害微生物引起的侵害。而自由基对人体的侵害也存在于人体整个生命过程,相对于有害微生物侵害,其强度较弱,节奏更慢,是一种无声无息的状态,但是最终表现出来的症状如胰腺出现问题导致糖尿病,心脏血管出现问题造成高血压,高血脂等问题会更严重,更难以恢复,所以两种内源性侵害中,有害微生物的侵害来得更快,更易于控制与身体恢复,而自由基侵害来得慢而柔,但是造成的损伤更难以恢复。

由上可知,当我们不小心被割伤时,这种外源性伤害将我们身体具体部位完全暴露在外,破坏了我们身体内内源性侵害保护系统,造成有害微生物对我们身体的侵害加强,被割伤部位会出现炎症,这个时候我们需要清理创口,然后包扎好,同时吃阿莫西林等消炎药来减少有害微生物对伤口的侵害,抑制炎症的发生。现在问题来了,阿莫西林之类的消炎药可以让你的伤口愈合吗?有些人说“会”。其实,消炎药不会让你的伤口愈合,它只会减少或抑制有害微生物对你的侵害,让你伤口愈合的原因是你机体的本能在起作用。我们的机体每天都在新陈代谢消耗物质,产生能量,供机体各种生理功能需要,包括消化吸收物质,合成蛋白质等过程,这个过程使得身体的伤口可以愈合。也就是说,阿莫西林不会让伤口愈合,让伤口愈合的是你机体自带的愈合功能。
理解了上述的内容,接下来我们来了解虾青素就容易了。

人体衰老的过程是一个自由基不停攻击人体细胞,人体细胞不停新陈代谢并修复更新的过程。当自由基攻击细胞损伤的程度强于人体自身修复更新的程度时,人体便会呈现衰老,机体功能衰退的现象,包括各种器官疾病的发生,如心脏病,肾病,肝病,肿瘤,皮肤病,皮肤变皱,产生暗斑,黑斑,睡眠变差,高血压等等。这个时候,或者更早时候,我们人体主动加强抗氧化营养素的摄入,加强体内抗氧化物质对体内自由基的淬灭,使人体自身修复更新的程度强于自由基攻击细胞损伤的程度,也即使得自由基攻击细胞损伤的程度弱于或远远弱于人体自身修复更新的程度。由此,通过人体的自我修复更新,人体原来呈现出来的衰老症状,包括各种疾病会慢慢得到缓解,病症得到改善,比如血压慢慢降低,可能直至恢复正常,睡眠质量慢慢变好,直至正常,皮肤暗斑黑斑慢慢变淡,直至正常。

综上,当人体自由基攻击细胞损伤的程度强于人体自身修复更新的程度时,人体呈现衰老现象,而在抗氧化营养素的干预下,当人体自由基攻击细胞损伤的程度弱于人体自身修复更新的程度时,人体可以保持机体功能稳定,身心健康的状态。
所以说,虾青素是抗氧化营养素,本身不会抗衰老,也不会美白祛斑,也不会改善你的记忆,畅通你的血管,能直接做到所有这一切的是你的机体自身恢复能力在起作用,而虾青素起的作用就是在你恢复机体自身机能的时候,把引起人体衰老,血管堵塞,记忆衰退,黑斑沉积等的的诱因给抑制住。这些,类似人体受伤时,人体自身机能在自愈时利用抗生素阻止外源细菌的侵害是一个道理。

可以说,虾青素是我们身体健康的保护神之一。当我们身体健康时,它能分布在我们身体里,通过淬灭身体生理过程产生的自由基来保护我们身体免受其侵害。当我们身体出现问题后恢复健康时,它也能通过淬灭身体生理过程产生的自由基来阻止自由基对我们身体的伤害。

所以,在身体机能有衰退迹象之前,我们适当补充一些外源性的抗氧化营养素,对于我们保持健康的身体和良好的精神状态很有必要,而虾青素是这种外源性抗氧化营养素的最好选择。所以说,虾青素的神不在于包治百病,而在于能与致病的自由基勇敢战斗奉献自我,保障身体健康。



